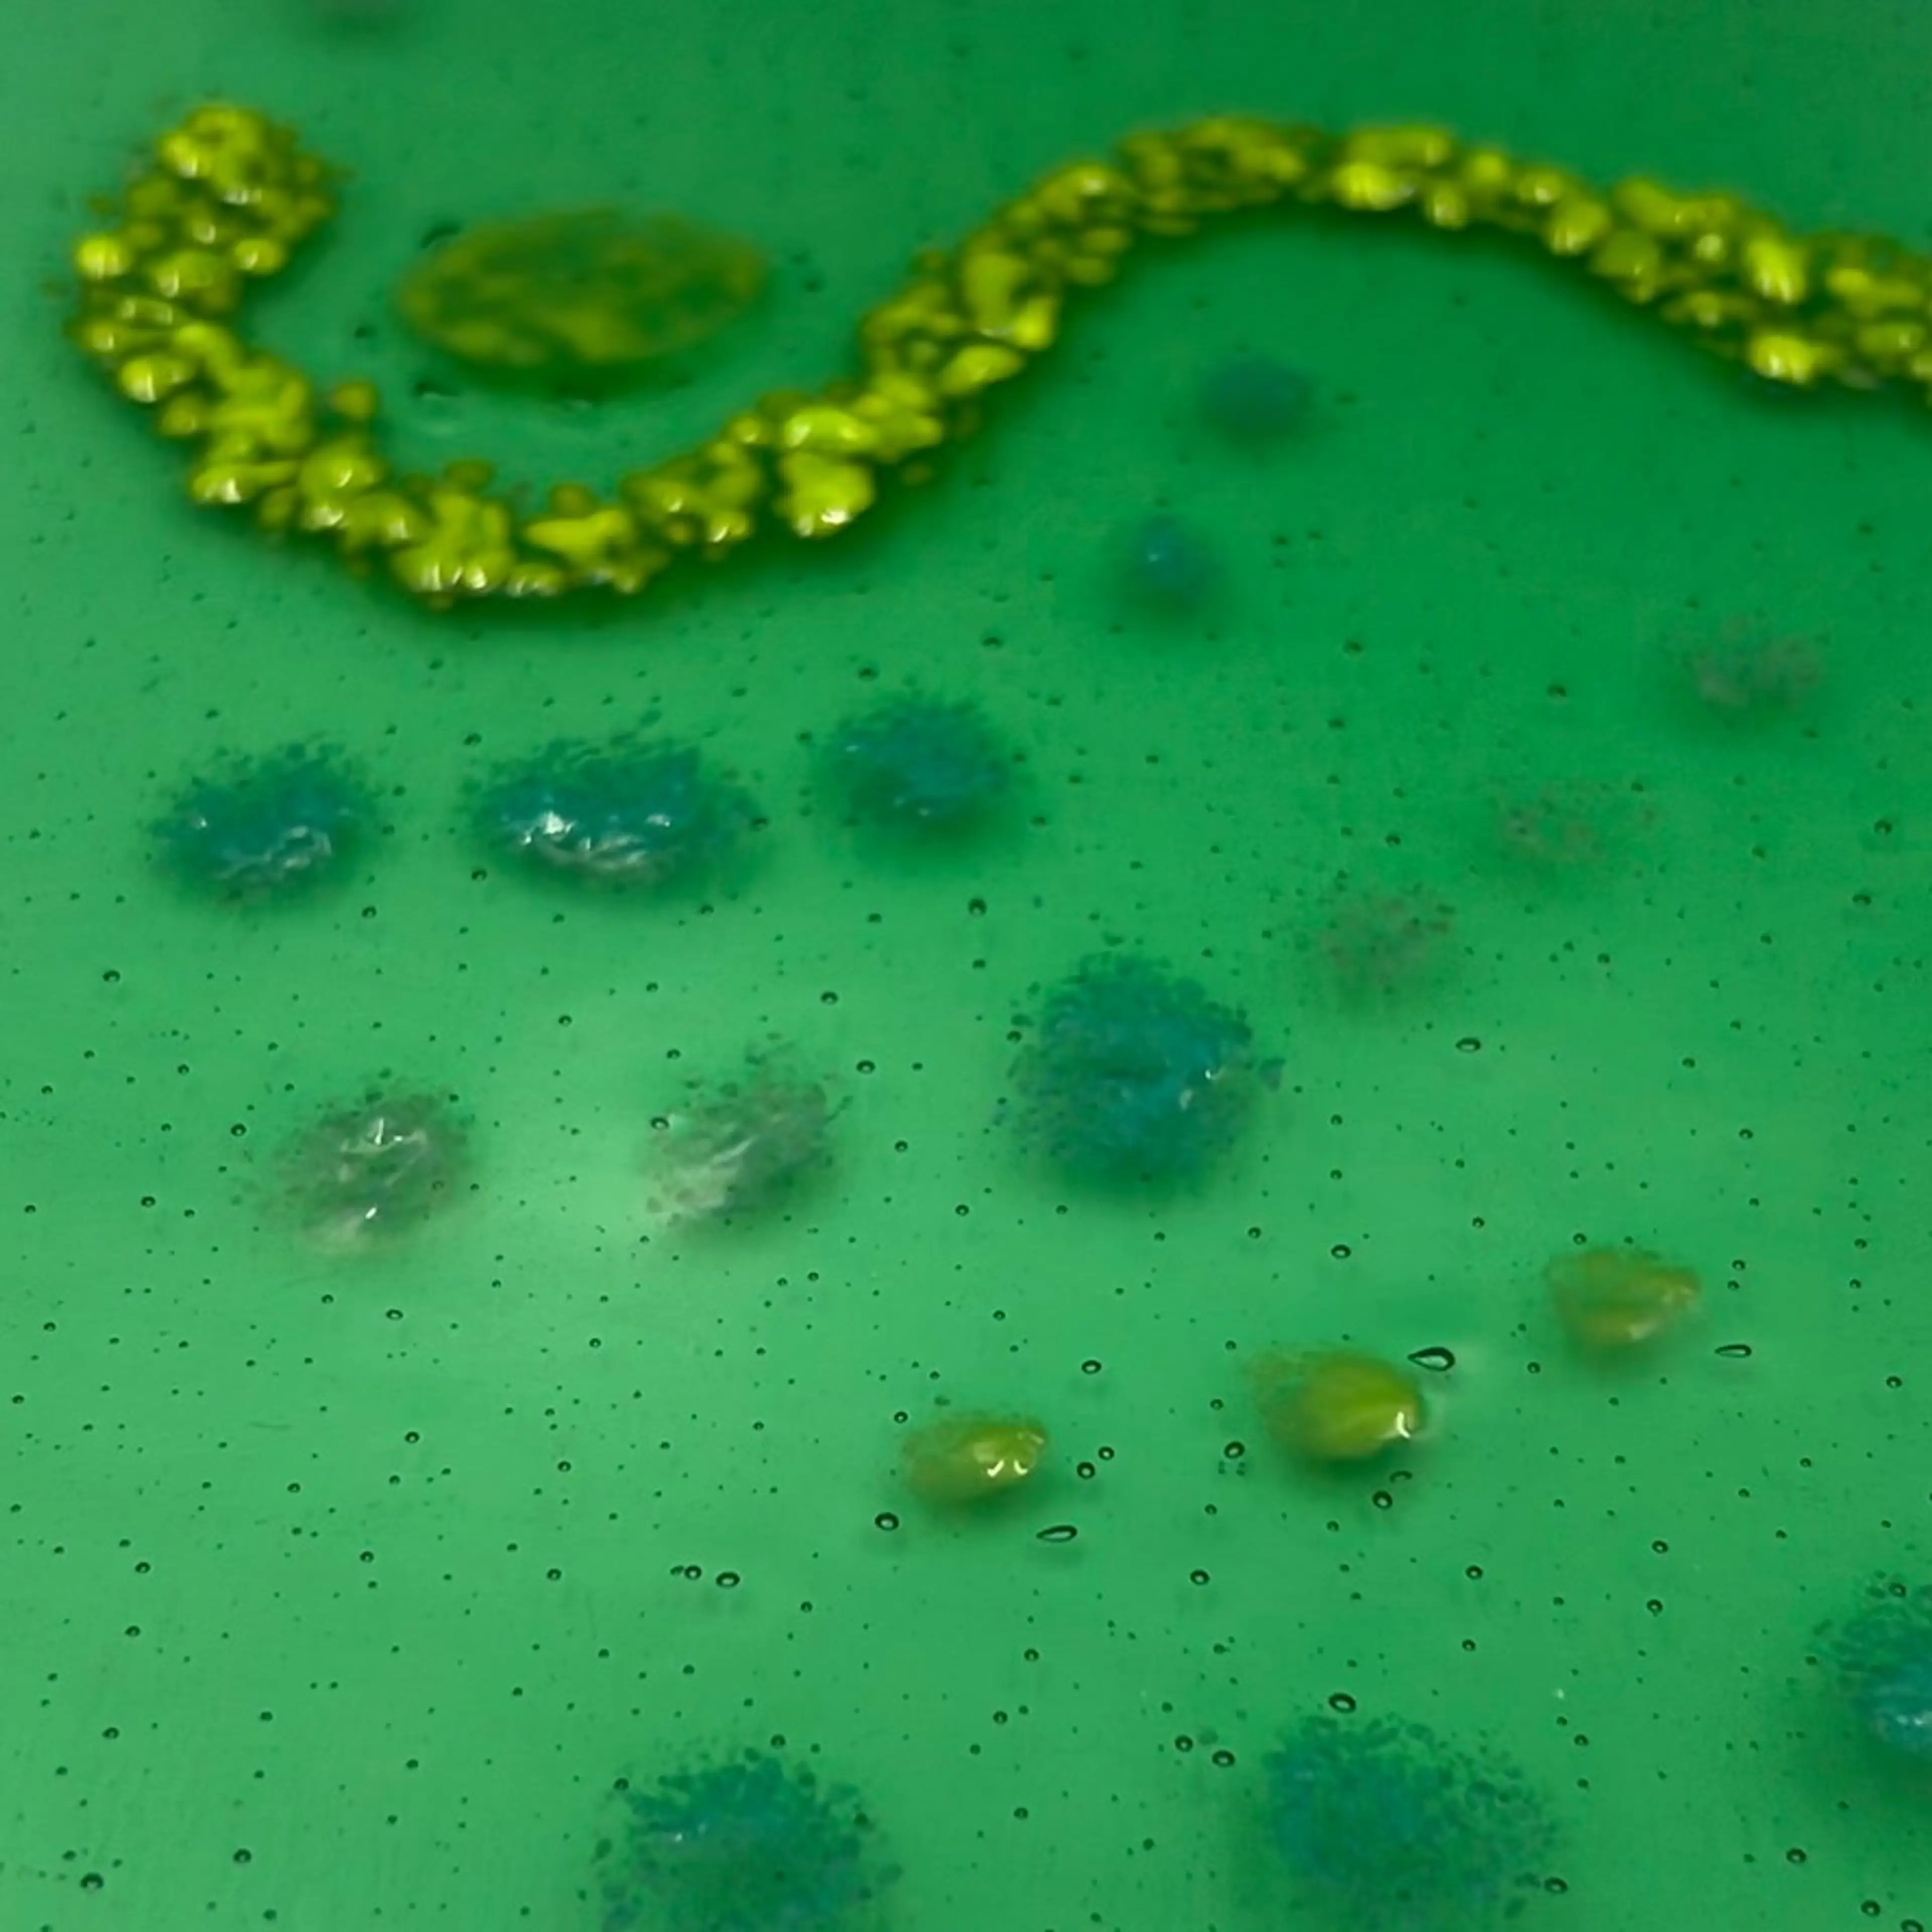
Image 2 of 5

Meet Your Seller
🌟First time buyers on NikNax✌️Use my code JERSEY12 at checkout for $5 off any purchase $10 or more! ⬆️ Click Follow to Get Notified of my Live Shows! 🏺I sell unique decor, jewelry and vintage items. 😻 I am a part-time seller, Live Sales (mostly on trains), auction and Buy It Now (BIN) 🙏 Thanks for your support. 😊 All sales final. ✌️All I want to know is Are You Kind🌹🎶
- Niknax seller since
- 335 Listings
- 3094th on Seller Leaderboard
- 438 Sales
- 1 days avg. time to ship
Product Gallery
Artisan Made Fused Glass Plate 9.75” x 10”
This is a work of art. A pale lime green glass with yellow and light blue glass accents. No signature. No damage.
- 13 views
- Listed Apr 6, 2025